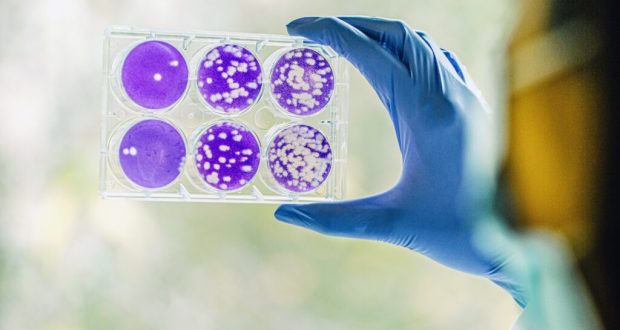

لينا إسماعيل:
بالرغم من الأهمية الحيوية لزراعة الخلايا الجذعية، بوصفها من أكثر العلاجات تقدماً لمرضى السرطان وأمراض الدم، لا يزال هذا الإجراء الطبي في سوريا محصوراً ضمن نطاق ضيق، سواء من حيث عدد المراكز المتخصصة أو القدرة الاستيعابية، ما يضع مرضى كثراً أمام معاناة قاسية في ظل تكاليف باهظة وغياب البدائل.
وتشير شكاوى مرضى وذويهم من مختلف المحافظات إلى أن مراكز زراعة الخلايا الجذعية لا تتوافر إلا في العاصمة دمشق، وبعدد محدود لا يتجاوز مركزين في القطاع العام ومركزاً خاصاً واحداً، وهو واقع لا يلبي الحاجة المتزايدة لمرضى سرطان الدم (الليمفوما)، وأمراض الدم الوراثية كالتلاسيميا، ونقص المناعة، والأمراض المؤدية إلى تلف نقي العظم.
علم متقدم وواقع متأخر
تُعدّ زراعة الخلايا الجذعية إجراءً طبياً متقدماً؛ يتم خلاله استبدال نقي العظم التالف بخلايا جذعية سليمة، بعد إخضاع المريض لجرعات عالية من العلاج الكيميائي أو الإشعاعي، ثم إعادة حقن خلايا جذعية ذاتية أو من متبرع متوافق، بهدف إعادة إنتاج خلايا دم سليمة.
ويُذكر أن مشفى الأطفال الجامعي في دمشق يعد أول مركز وطني لزراعة الخلايا الجذعية الدموية مجاناً لمرضى السرطان من الأطفال، إلى جانب مركز “المشفى العسكري” بدمشق الذي كان مخصصاً لزراعة الخلايا الجذعية للبالغين، إضافة إلى المجموعة السورية لزرع النقي والخلايا الجذعية الدموية، في المقابل، تغيب هذه المراكز كلياً عن بقية المحافظات.
شبح الموت على لوائح الانتظار
من حلب، تروي ثريا شويحنة معاناة عائلتها، موضحة أن والدتها كانت بحاجة ماسة إلى زراعة خلايا جذعية، باعتبارها الفرصة الوحيدة للنجاة، إلا أن التكاليف في القطاع الخاص بلغت نحو 300 مليون ليرة سورية، بينما يقتصر الزرع الحكومي على دمشق، مع توقف المركز في فترة من الفترات، فتوفيت والدتها قبل أشهر، وتقول: “لو كان البيت ملكاً لنا لبعناه وأجرينا العملية، لكننا كنا نسكن بالإيجار، فماذا كنا سنبيع؟”.
بدوره، طالب مصطفى نصر بإحداث مراكز إضافية تابعة لوزارة الصحة في المحافظات، لتخفيف معاناة المرضى، ولا سيما في المناطق الشمالية، حيث يضطر بعضهم للتوجه إلى محافظة الرقة لإجراء الزرع على يد طبيب يزور المنطقة مرة واحدة شهرياً، مشيراً إلى أن تكلفة الإجراء في حد ذاتها مرتفعة، ما يجعل السفر عبئاً إضافياً.
أما إياد قورة من دمشق، فتحدث عن معاناته الحالية في تأمين تكاليف الزرع، لافتاً إلى رغبة عدد من المغتربين في دعم القطاع الصحي، مقابل وجود عوائق إدارية تحتاج إلى معالجة لتسهيل مساهماتهم في توفير خدمات علاجية أفضل.
إجابات مختصرة وملف ثقيل
وبالاستفسار من وزارة الصحة، أوضح المكتب الإعلامي في الوزارة أن واقع زراعة الخلايا الجذعية معقد، مؤكداً أن الوزارة تدرس هذه المطالب وتسعى لإيجاد حلول مناسبة.
كما بين مدير صحة حلب الدكتور محمد وجيه جمعة أن هذه المراكز تحتاج إلى خبرات عالية وتجهيزات متطورة غير متوافرة حالياً في حلب والمحافظات الشمالية.
ولتوضيح واقع هذا الإجراء ومعوقاته، أوضحت الدكتورة زاهرة فهد، المتخصصة في زراعة الخلايا الجذعية، أن تأخر زرع النقي في سوريا يعود إلى الحاجة لبنية تحتية متكاملة وخبرات متعددة، تشمل بنوك دم متقدمة، ومخابر تطابق نسيجي لإجراء التحاليل الجينية والفيروسية، وتجهيزات غرف عزل معقمة ذات تهوية خاصة، إضافة إلى توفير أدوية الزرع.
وأضافت أن هذا الإجراء يتطلب كوادر متعددة التخصصات؛ من أطباء سريريين ومخبريين وأطباء بنك دم وأطباء مختصين بالأمراض الإنتانية، فضلاً عن خبرة طويلة في متابعة المرضى بعد الزرع ومراقبة حالات الرفض والتقبل، مع استشفاء طويل وعناية مشددة.
تكاليف مرتفعة وإمكانات محدودة
وأوضحت فهد أن تكاليف زراعة النقي مرتفعة جداً، إذ تبلغ في أوروبا وأميركا نحو 500 ألف دولار، وفي دول الجوار قرابة 200 ألف دولار، بينما تصل تكلفة الزرع الذاتي إلى نحو 50 ألف دولار.
وأشارت إلى أن الواقع الحالي غير مشجع، في ظل غياب أي قسم لزرع النقي للكبار بعد توقف مركز “المشفى العسكري” بدمشق، واقتصار زرع الأطفال على مركز وحيد في مشفى الأطفال الجامعي، مع عدم وجود مشاريع حكومية جديدة في الأفق.
وأضافت أن عدد غرف الزرع في المراكز الخاصة تقلص، ولا يوجد بنك وطني للخلايا الجذعية أو برنامج وطني للزرع، كما لا تغطي شركات التأمين الصحي تكاليف هذا الإجراء، ولا تتوافر مخابر وبنوك دم قادرة على تلبية متطلباته، رغم حاجة البلاد إلى ما لا يقل عن خمسة مراكز زرع تضم نحو 50 إلى 60 سريراً.
وأشارت فهد إلى أن فكرة زرع الخلايا الجذعية بدأت في سوريا مطلع تسعينيات القرن الماضي، لكن الانطلاقة الفعلية تأخرت حتى عام 2008 بعد دراسات ومناقصات طويلة لتأمين التمويل، وخلال سنوات الثورة، توقف مركز “المشفى العسكري” بدمشق، واضطر المرضى للسفر إلى دول الجوار أو الخارج، ما حمّلهم أعباء مالية إضافية نتيجة طول فترة الإقامة والحاجة لمرافقة العائلة.
في ظل هذه المعطيات، تبدو زراعة الخلايا الجذعية في سوريا ملفاً مؤجلاً رغم أهميته الطبية والإنسانية، ما يستدعي دعماً حكومياً لتأمين البنية التحتية والكوادر والتجهيزات، وتفعيل بنوك وطنية للخلايا الجذعية، إلى جانب تعزيز التعاون مع الجهات الدولية والمانحة، بما يتيح للمرضى الوصول إلى العلاج ويعيد الأمل لمن يواجهون المرض في ظروف تفوق قسوته.
أخبار سوريا الوطن١-الثورة
 syriahomenews أخبار سورية الوطن
syriahomenews أخبار سورية الوطن